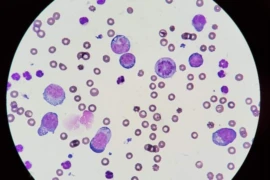

Anja Ewringmann
DVM

Anja Ewringmann
DVM
1989-1995: Studium in Budapest und Berlin
1995-2000: Kleintierklinik FU Berlin, Arbeitsgruppe für Heimtiere, Exoten u. Wildtiere
1998: Promotion: Untersuchungen zur Klinik, Diagnose und Therapie von Infektionen mit E. cuniculi beim Heimtierkaninchen
2000-2007: Assistenz in versch. Kleintierpraxen und –kliniken
2006: Zusatzbezeichnung Heimtiere
Seit 2007: niedergelassen in eigener Praxis für kleine Heimtiere
Webinare

Anja Joachim
Univ. Prof. DVM, Dipl. EVPC

Anja Joachim
Univ. Prof. DVM, Dipl. EVPC
Prof. Dr. Anja Joachim hat an der Tierärztlichen Hochschule Hannover Veterinärmedizin studiert und sich im Fach Parasitologie habilitiert. Sie ist seit 2003 Professorin an der Veterinärmedizinischen Universität Wien und Leiterin des Instituts für Parasitologie. Ihr Forschungsfokus sind Wirt-Parasit-Interaktionen in Haustieren und moderne Kontrollstrategien gegen Parasiten. Sie ist Mitglied in zahlreichen Fachgruppen, Vorstandsmitglied der Weltgesellschaft der Veterinärmparasitologen und Diplomate des European Veterinary Parasitology Colleges. Sie hat bisher vier College-Residents, acht PhDs und zehn Dr. med. vet. Studierenden ausgebildet und >200 Originalpublikationen und Übersichtsartikel in Fachzeitschriften verfasst.
Webinare

Anna Draschka
DVM, EMSAVM Dentistry

Anna Draschka
DVM, EMSAVM Dentistry
• Tiermedizinstudium an der LMU München von 1999-2005
• Während Schule und Studium Stuhlassistenz in einer humanen Zahnarztpraxis - hier wurde vermutlich der Grundstein für das große Interesse an Zahnheilkunde gelegt
• Promotion an der Universität Leipzig 2008
• 2005-2009 Assistenzzeit in verschieden Praxen und Kliniken
• Vor 15 Jahren erfolgte die Gründung der Tierarztpraxis Hadern, Dr. Draschka mit Tätigkeitsschwerpunkt Zahnheilkunde in München Hadern - mittlerweile überregionale Überweisungspraxis für Zahnheilkunde und kleine Heimtiere
• 2021 ÖTK Diplom Zahn- und Kieferchirurgie für Klein- und Heimtiere
• 2018 - 2023 Studium im internationaler Master Studiengang Tierzahnheilkunde an der Universität von Luxemburg, Abschluss im Februar 2023:
European Master Small Animal Veterinary Medicine Dentistry
• Chefredakteurin der 3 Fachmagazine im Mollmedia Verlag für den Bereich Zahnheilkunde und kleine Heimtiere
• Referententätigkeiten auf nationalen und internationalen Fortbildungen und Kongressen im Bereich Zahnheilkunde und CBCT
Webinare

Anna Ehrle
DVM

Anna Ehrle
DVM
Qualifikationen:
• Diplomate ECVS und ECVSMR
• Fachtierärztin für Pferde und Pferdechirurgie WBE
• DVM CertAVP (ESO/ESST/VDI/CP) - Certificate in Advanced Veterinary Practice (Equine Surgery – Orthopaedics / Soft tissue; Veterinary diagnostic imaging; Camelid practice)
• MRCVS - Member of the Royal College of veterinary Surgeons
• Zusatzbezeichnung Tierärztliche Betreuung von Pferdesportveranstaltungen und FEI treating veterinarian
• Zusatzausbildung Chiropraktik IAVC
Werdegang:
• Aktuell: Mitarbeiterin der Pferdeklinik der FU Berlin – Abteilung Chirurgie / Orthopädie
o Forschungsschwerpunkt: Biomechanik und Innervation der thorakolumbalen Wirbelsäule
• 2014 – 2018 ECVS Residency in equine surgery an der University of Liverpool, Philip Leverhulme Equine Hospital
• 2012 – 2014 Assistenzzeit Pferdefahrpraxis in Devon, UK mit Auslandseinsätzen in Hong Kong und China
• 2010 – 2012 Internship und Promotion zum Thema 'Osteoarthritis beim Pferd' an der Pferdeklinik der FU Berlin
• 2007 – 2010 Studentische Hilfskraft in der Pferdeklinik der FU Berlin
• 2004 – 2010 Studium der Veterinärmedizin an der FU Berlin
Webinare

Anna-Lena Ziese
DVM

Anna-Lena Ziese
DVM
Anna-Lena Ziese studierte Tiermedizin an der Ludwig-Maximilians-Universität (LMU) München und erhielt im April 2017 ihre Approbation. Von Juli 2017 bis Juni 2019 war sie als wissenschaftliche Hilfskraft im Gastroenterologie-Service der Medizinischen Kleintierklinik tätig. Dabei setzte sie sich umfassend mit Erkrankungen des Magen-Darm-Traktes (vor allem mit dem akuten hämorrhagischen Diarrhö-Syndrom des Hundes und chronischer Enteropathie), der Leber und des Pankreas auseinander sowie diätetischen Herausforderungen, die diese Erkrankungen mit sich bringen.
Von Juli bis September 2019 arbeitete Anna-Lena Ziese im internistischen Team. Seit Oktober 2019 arbeitet sie in der Ernährungsberatung der Medizinischen Kleintierklinik schwerpunktmäßig in der Weight-Management-Sprechstunde.
Parallel fertigt sie seit Juli 2017 ihre Doktorarbeit an. Im Rahmen ihrer Promotion führte sie unter anderem eine Studie zu „Probiotika-Therapie bei Hunden mit akutem hämorrhagischen Durchfall“ durch.
Webinare

Anne Couroucé-Malblanc
DVM

Anne Couroucé-Malblanc
DVM
Anne Couroucé-Malblanc est docteur vétérinaire, titulaire d'un doctorat universitaire et diplômée du Collège Européen de Médecine Interne Equine. Elle a travaillé de 1992 à 2001 en médecine sportive pour les chevaux de course et de sport et a développé une consultation d'évaluation de la contre-performance sur le tapis roulant ciblé sur l'appareil respiratoire, cardio-vasculaire et musculaire. Depuis 2001, elle travaille en tant que maître de conférences en médecine interne équine à Oniris, école vétérinaire de Nantes. Ses centres d'intérêt en recherche sont les affections des voies respiratoires et plus récemment l'hémorragie pulmonaire induite à l'exercice chez le Trotteur. De Février 2013 à Septembre 2014, elle a été la vétérinaire coordinatrice des Jeux Equestres Mondiaux qui se sont tenus en France, en Normandie.
Webinare

Anne Fawcett
DVM, BA (Hons), BSc (Vet)(Hons), BVSc (Hons), MVetStud, GradCertEdStud(Higher Ed) MANZVCS (Animal Welfare) DipCAWBM (AWSEL)

Anne Fawcett
DVM, BA (Hons), BSc (Vet)(Hons), BVSc (Hons), MVetStud, GradCertEdStud(Higher Ed) MANZVCS (Animal Welfare) DipCAWBM (AWSEL)
Anne Fawcett is a companion animal veterinarian and lecturer in the Sydney School of Veterinary Science. She is a Member of the Australian and New Zealand College of Veterinary Scientists Animal Welfare Chapter, and a Diplomat of the European College of Animal Welfare and Behaviour Medicine (Animal Welfare Science, Ethics and Law). She co-wrote Veterinary Ethics: Navigating Tough Cases with Dr Siobhan Mullan (2017:5M). She is a member of the Australian Veterinary Palliative Care Advisory Council <link https: www.avpcac.com>https://www.avpcac.com/.
Anne is keenly interested in the application of animal welfare science and ethical theory at the coalface of veterinary practice, where real decisions must be made with an incomplete dataset in an imperfect world. She is also passionate about the wellbeing of those who look after animals, including veterinarians and nurses, and was one of the co-editors of the Vet Cook Book (2017:CVE). She is currently undertaking a PhD on ethically challenging situations experienced by veterinarians, animal health technicians and veterinary nurses.
Webinare

Anne Fowler
DVM, BSc(Vet)(Hons), BVSc, MANZCVS (Avian health, Wildlife health, Unusual pet medicine)

Anne Fowler
DVM, BSc(Vet)(Hons), BVSc, MANZCVS (Avian health, Wildlife health, Unusual pet medicine)
Dr. Anne Fowler graduated from Sydney University in 1993 after completing an honours year looking at Vitamin D metabolism in marsupials. She has worked in a variety of mixed and small animal practices as well as working at Healsville Sanctuary and the University of Sydney's Wildlife health and Conservation Centre as a clinical registrar. In 2015, she opened the Adelaide Bird and Exotics Vet Centre which is the South Australia's first clinc seeing only pocket pets, birds and wildlife. Anne has been teaching wildlife carers in wildlife rehabiliation since 2020 and has produced several manuals on wildlife care.
Webinare

Anne Kramer
DVM, Cert. AVP (camelid)

Anne Kramer
DVM, Cert. AVP (camelid)
Ich bin gebürtige Niederländerin und hab in 2006 mein Studium der Veterinärmedizin in Utrecht abgeschlossen. Auf der Suche nach dem großen Abenteuer, bin ich direkt nach Neuseeland ausgewandert, wo ich in der Großtierpraxis und als Lehrerin an der Massey Universität arbeitete. Schon in Neuseeland hatte ich ein großes Interesse an Neuweltkameliden. Von 2010 bis 2014 war ich am Tierspital Bern tätig als Tierärztin, Forscherin, Klinikkoordinatorin und Dozentin. Auch da hab ich mich immer gerne um die 2 Alpakas und Lamas gekümmert. Bis Mitte 2016 war ich zurück in Neuseeland, bevor ich im Sommer von 2016 definitiv in die Schweiz gekommen bin. Nach ein paar Jahren als Assistentin in einer Großtierpraxis in der Nähre von Bern, habe ich am 1. Januar 2019 entschieden, mich 100% selbständig der Neuweltkamelidenmedizin zu widmen. In 2022 habe ich die Ausbildung zur Neuweltkamelidenspezialistin an der Universität von Liverpool absolviert und und seitdem bin ich die einzige Spezialistin für Lamas und Alpakas in der Schweiz.
Webinare

Anne Strattner
DVM

Anne Strattner
DVM
Anne Strattner hat von 1993-1999 an der Tierärztlichen Hochschule (TiHo) in Hannover studiert und anschließend dort promoviert. Aktuell ist sie bei der Ecuphar GmbH als Produktmanagerin tätig und betreut dort u.a. ein patentiertes neues NSAID für Hunde. Im Anschluss an die Promotion war sie zunächst einige Zeit als angestellte Tierärztin in einer Gemischtpraxis in Schleswig-Holstein beschäftigt, bevor sie eine Weiterbildung zur Referentin für Öffentlichkeitsarbeit & PR absolvierte und anschließend als Wissenschaftliche Mitarbeiterin den „XXVIIth International Congress of the International Union of Game Biologists – IUGB“ am Institut für Wildtierforschung der TiHo organisierte. Eine Position bei einer Fachagentur für Agrar und Veterinär war schließlich das Sprungbrett für den Wechsel in die Industrie und zur Wirtschaftsgenossenschaft deutscher Tierärzte WDT. In den Jahren 2020-2021 war Anne Strattner Chefredakteurin der Fachzeitschrift „Der Praktische Tierarzt“.
Webinare

Anne-Katherine Jasensky
DVM, Dipl ECVCP, MRCVS

Anne-Katherine Jasensky
DVM, Dipl ECVCP, MRCVS
2005 – 2011: Studium der Veterinarmedizin, Freie Universitaet (FU) Berlin
2011: Rotierendes Internship an der Klinik und Poliklinik für kleine Haustiere, FU Berlin
2012 – 2014: Doktorarbeit und Wissenschaftliche Mitarbeiterin am Institut für VeterinärBiochemie, FU Berlin
2014 – 2015 Wissenschaftliche Mitarbeiterin (Post-Doc) am Institut für Veterinär-Biochemie, FU Berlin
2016 – 2019: Residency in Veterinary Clinical Pathology (ECVCP), Laboklin GmbH & Co KG
Seit 2020: Lecturer for Veterinary Clinical Pathology am Royal Veterinary College (RVC) London
Seit 2023: Dozentin für das Veterinary Information Network (VIN)
Webinare

Anneka Pierzga
BA (Biology), AAS (MLT), MLT (ASCP), RVN, TAA

Anneka Pierzga
BA (Biology), AAS (MLT), MLT (ASCP), RVN, TAA
Anneka completed a Bachelor of Arts in Biology from St. Mary’s College of Maryland in 2011, and then went on to train on-the-job as a veterinary technician in Maryland, USA. Since then, she has worked in a wide variety of veterinary clinical settings including small animal general practice, wildlife rehabilitation, biomedical research/laboratory animal medicine and emergency and referral medicine. Over the course of this journey, she discovered a love for the fast and ever-changing pace of emergency and critical care medicine, as well as a keen interest in clinical pathology. This led her to return to university to study medical laboratory technology, and she qualified with the American Society for Clinical Pathology in 2017.
Anneka moved to Western Australia and qualified as a Registered Veterinary Nurse in 2018, where she now spends her time split between working as an ECC nurse in a busy emergency and referral centre just outside of Perth along with working as a Nurse Educator for ACVN.
Anneka’s special interests include emergency and critical care nursing, clinical pathology, transfusion medicine, and the application of critical thinking and passion to deliver high quality nursing care.
Webinare

Annett-Carolin Häbich
DVM

Annett-Carolin Häbich
DVM
Dr. Annett-Carolin Häbich studierte Veterinärmedizin an der Tierärztlichen Hochschule Hannover. Sie graduierte 2002 und schrieb im Anschluss ihre Doktorarbeit zur Ernährung von Loris („Pinselzungenpapageien“).
In den Jahren 2005/06 arbeitete sie als Bestandstierärztin für den Loro Park; dort war sie für die medizinische Betreuung unzähliger Papageien und Sittiche zuständig.
Im Anschluss kehrte sie nach Hannover zurück um dort ihre Fachtierarztausbildung (Tierernährung) zu machen. Ihre fortwährende Begeisterung für Vögel ließ sie jedoch wieder eine Stelle im Vogelmedizin-Bereich an der Vetmeduni Wien annehmen; hier arbeitete sie weitere 5 Jahre mit Zier- und Wildvogelpatienten aber auch Ziergeflügel.
Seit 2017 betreibt Frau Dr. Häbich ihre eigene Tierarztpraxis in Wien; diese bietet – „no na“ - eine Spezialsprechstunde für Vogelpatienten an.
Webinare

Annika Bremhorst
DVM, PhD

Annika Bremhorst
DVM, PhD
Annika Bremhorst ist promovierte Verhaltensbiologin und Wissenschaftlerin an der Universität Bern. Ihr Forschungsschwerpunkt liegt auf dem emotionalen Erleben und Schmerzverhalten bei Hunden und Pferden, sowie auf modernen Methoden der Verhaltensanalyse, einschließlich KI-gestützter Verfahren. Neben ihrer wissenschaftlichen Tätigkeit engagiert sie sich in der Wissenschaftskommunikation und leitet die Plattform Dogs and Science (www.dogsandscience.com), die Wissen aus der Verhaltensforschung über Hunde für Praxis und Öffentlichkeit zugänglich macht.
Webinare

Anthony Caiafa
Adjunct Professor, BVSc, BDSc, MANZCVS

Anthony Caiafa
Adjunct Professor, BVSc, BDSc, MANZCVS
Dr Caiafa is both a registered veterinarian and human dentist and currently works in both fields on the Sunshine Coast. He is an Associate Professor in Veterinary Dentistry at the University of Melbourne and a guest lecturer in Veterinary Dentistry at James Cook University, Townsville. Dr Caiafa has over 20 years experience in the field of Veterinary Dentistry and has lectured around the world in this discipline. Tony will happily accept referrals related to small animal oral diseases including jaw fracture repair and the management of oral growths.